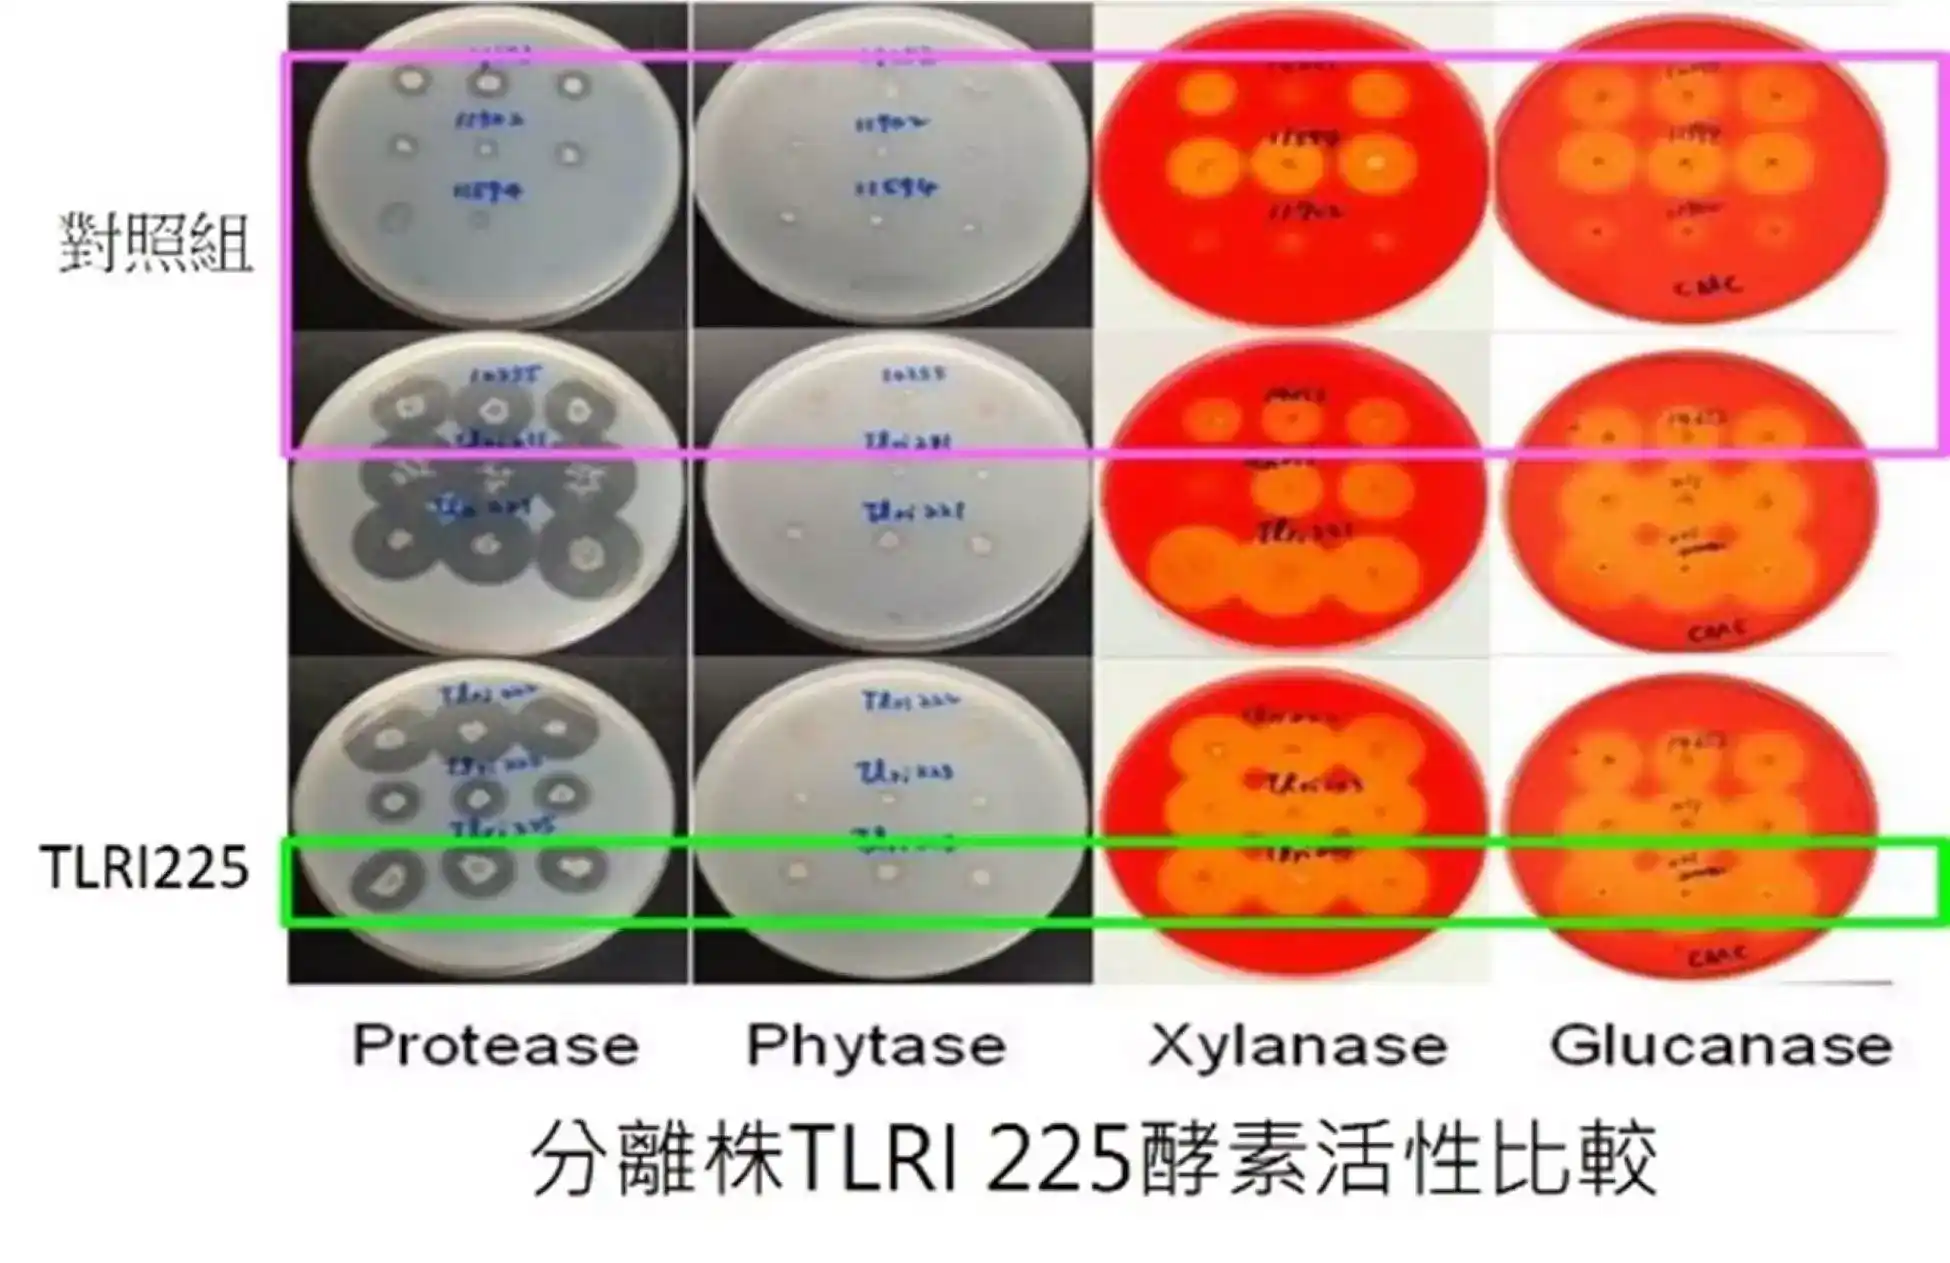
分離株TLRI 225酵素活性比較

技術概述
本菌株篩選自活性污泥,經16S rRNA基因序列比對,歸類為地衣芽孢桿菌,編號TLRI 225,屬飼料添加物正面表列微生物,亦為「已被鑑定為安全之微生物肥料菌種」。具有多種胞外酵素活性如蛋白酶、聚木糖酶、聚葡萄糖酶及植酸酶等,亦具酸耐受性與膽鹽耐受性,可當作飼料用益生菌與青貯菌,或用於農業剩餘物之分解,製作微生物肥料,除減少農業剩餘資源外並加值利用。
合作方式
專利授權
技術轉移
技術開發或輔導單位
農業部畜產試驗所
廖仁寶研究員 06-5911211
#2230
liawrb@mail.tlri.gov.tw